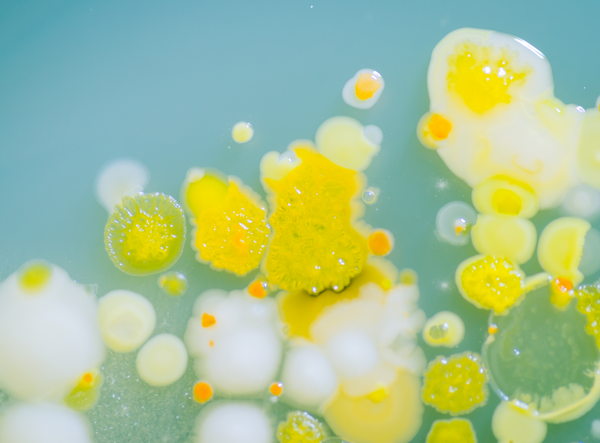

Master the Microbiome
Gut Microbiome
Webinar Series
M-SCI
Microbiomics Made Simple
At Zymo Research we strive to empower microbiome researchers worldwide to achieve their research goals, through unbiased microbial profiling, highly reproducible data, and scientist-to-scientist interaction. We are committed to leveraging our expertise to develop and deliver the highest quality kits, tools, and services, enabling our customers to achieve their research goals with confidence. Our focus on simplicity ensures that researchers of all levels can easily integrate our solutions into their workflows, accelerating their microbiome discoveries and advancing the field.
Where Microbiome Science Meets Application
Dive into curated content showcasing how microbiome tools and
approaches are advancing research across disciplines.
Any Step, Any Sample Type
Complete your workflow with the only comprehensive portfolio on the market.





Analysis

Microbiome Standards
Improve the quality and reproducibility of microbiomics analyses with microbial standards from Zymo Research.
- #1 Most Cited – Recognized in over 1100 publications
- Cross-validated with multiple quantification methods
- Different controls to suit a variety of applications
Companion tools are also available for our standards, including the MIQ Score Portal and Fecal Reference Database.
Products
Positive extraction controls for extraction validation
Controls for library prep in the form of purified DNA
Microbiome quality controls made from real sample material
In situ controls for sequencing-based microbiome measurements

Sample Collection
Collection kits and devices using ground-breaking reagent technology to inactivate pathogens and protect nucleic acid content.
- Remove the need for cold chain in shipping.
- Inactive potential pathogens for safe handling.
- Easy-to-use devices available for most common sample types.
Products
DNA and RNA stabilization solutions for nucleic acids in any biological sample.
DNA/RNA Shield preservation technology, provided in a variety of formats to suit a variety of sample types.
Spill-proof collection devices for reliable at-home sample collection.
Addons to facilitate ease of collection for complex sample types.

DNA/RNA Extraction
Improve the accuracy of your data with the most robust lysis and purification technologies available.
- Unbiased lysis of bacteria, archaea, fungi, and viruses.
- Certified low-bioburden reagents to reduce "kit-ome".
- Complete removal of downstream PCR inhibitors.
Products
Low-bioburden reagents and unbiased lysis technology to ensure complete DNA recovery and accurate microbial profiling.
Low-bioburden reagents and unbiased lysis technology to ensure complete DNA recovery and accurate metatranscriptomic profiling.
Automation-ready extraction to increase throughput, reduce handling requirements, and shorten turnaround times.
Streamlined host depletion and bacterial DNA isolation from mammalian samples.

Library Preparation
Optimized NGS library prep workflows that dramatically reduce hands-on time required to produce sequencing-ready libraries.
- The simplest and fastest NGS library prep workflows available.
- Pool libraries by equal volume, no tedious normalization required.
- UDI barcodes provide better demux accuracy and prevent index swapping.
Products
The simplest, fastest kits for sequencing-ready 16S/ITS amplicon sequencing libraries.
- Quick-16S NGS Library Prep Kit D6400
- Quick-16S Plus NGS Library Prep Kit (V1-V2) D6434
- Quick-16S Plus NGS Library Prep Kit (V1-V3) D6440
- Quick-16S Plus NGS Library Prep Kit (V3-V4) D6421
- Quick-16S Plus NGS Library Prep Kit (V4) D6430
- Quick-ITS Plus NGS Library Prep Kit (ITS2) D6425
- Quick-16S Full-Length Library Prep Kit D6450
Concentrate low-biomass samples, clean up dirty extractions, and remove pesky downstream enzymatic inhibitors.

NGS Analysis
A variety of sequencing services and analysis tools to help you find the answers you seek.
- Microbiome Analysis Services for Any Application.
- Free analysis tools to accelerate your metagenomics research.
- Databases to host and share sequencing data and meta-data.
Tools & Services
Complete Solutions for all your sequencing needs, using the most accurate microbiome profiling methods.
Accelerate your research with free metagenomics research tools.
Public platforms designed to host NGS characterization data generated specifically from the ZymoBIOMICS reference materials.
Find Your Custom Microbiome Workflow Today
Please select your Sample Type, Extraction, and Application.
The Workflow Generator will then generate a custom workflow based on your selection.
During the pilot launch, we're enhancing the Workflow Generator to provide tailored product recommendations for your research. We value your feedback and encourage suggestions as you use the tool—your input will help us improve the experience! Contact Us!
Webinars
Knowledge Center
Featured Technologies
NGS Services
Trusted By Leading Institutions
Testimonials from Our Customers

- choosing a selection results in a full page refresh
Need help? Contact Us